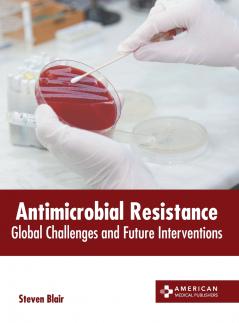
Antimicrobial Resistance

English
Hardback
₹13437
₹16886
20.43% OFF
(All inclusive*)
Delivery Options
Please enter pincode to check delivery time.
*COD & Shipping Charges may apply on certain items.
Review final details at checkout.
Looking to place a bulk order? SUBMIT DETAILS
Delivery Options
Please enter pincode to check delivery time.
*COD & Shipping Charges may apply on certain items.
Review final details at checkout.
About The Book
Description
Author
Antimicrobial resistance (AMR) happens when microbes develop mechanisms that guard them against the outcomes of antimicrobials. The agents that kill or stop the growth of microorganisms are called antimicrobials. The classification of antimicrobials is based on their function. For instance antibiotics are used against bacteria and antifungals are used against fungi. The main causes of rising antimicrobial resistance are the usage of antimicrobials in humans and other animals and the dissemination of resistant strains between the two. The multifold rise in resistance has also been related to the pharmaceutical sector releasing insufficiently treated effluents in the environment particularly in nations where bulk medicines are made. Antimicrobials boost selective pressure in microbial populations leading to the death of vulnerable microorganisms. This results in a rise in the percentage of resistant bacteria that survive. Resistant bacteria usually have a growth advantage and proliferate faster than vulnerable bacteria even at very low levels of antibiotics. Antimicrobial resistance is becoming more widespread necessitating the development of alternate treatments. The aim of this book is to present researches that have transformed the study of antimicrobial resistance and aided its advancement. It will help the readers in keeping pace with the rapid changes in this field of study.
Details
ISBN 13
9781639278862
Publication Date
-26-09-2023
Pages
-242
Weight
-732 grams
Dimensions
-216x280x14.29 mm